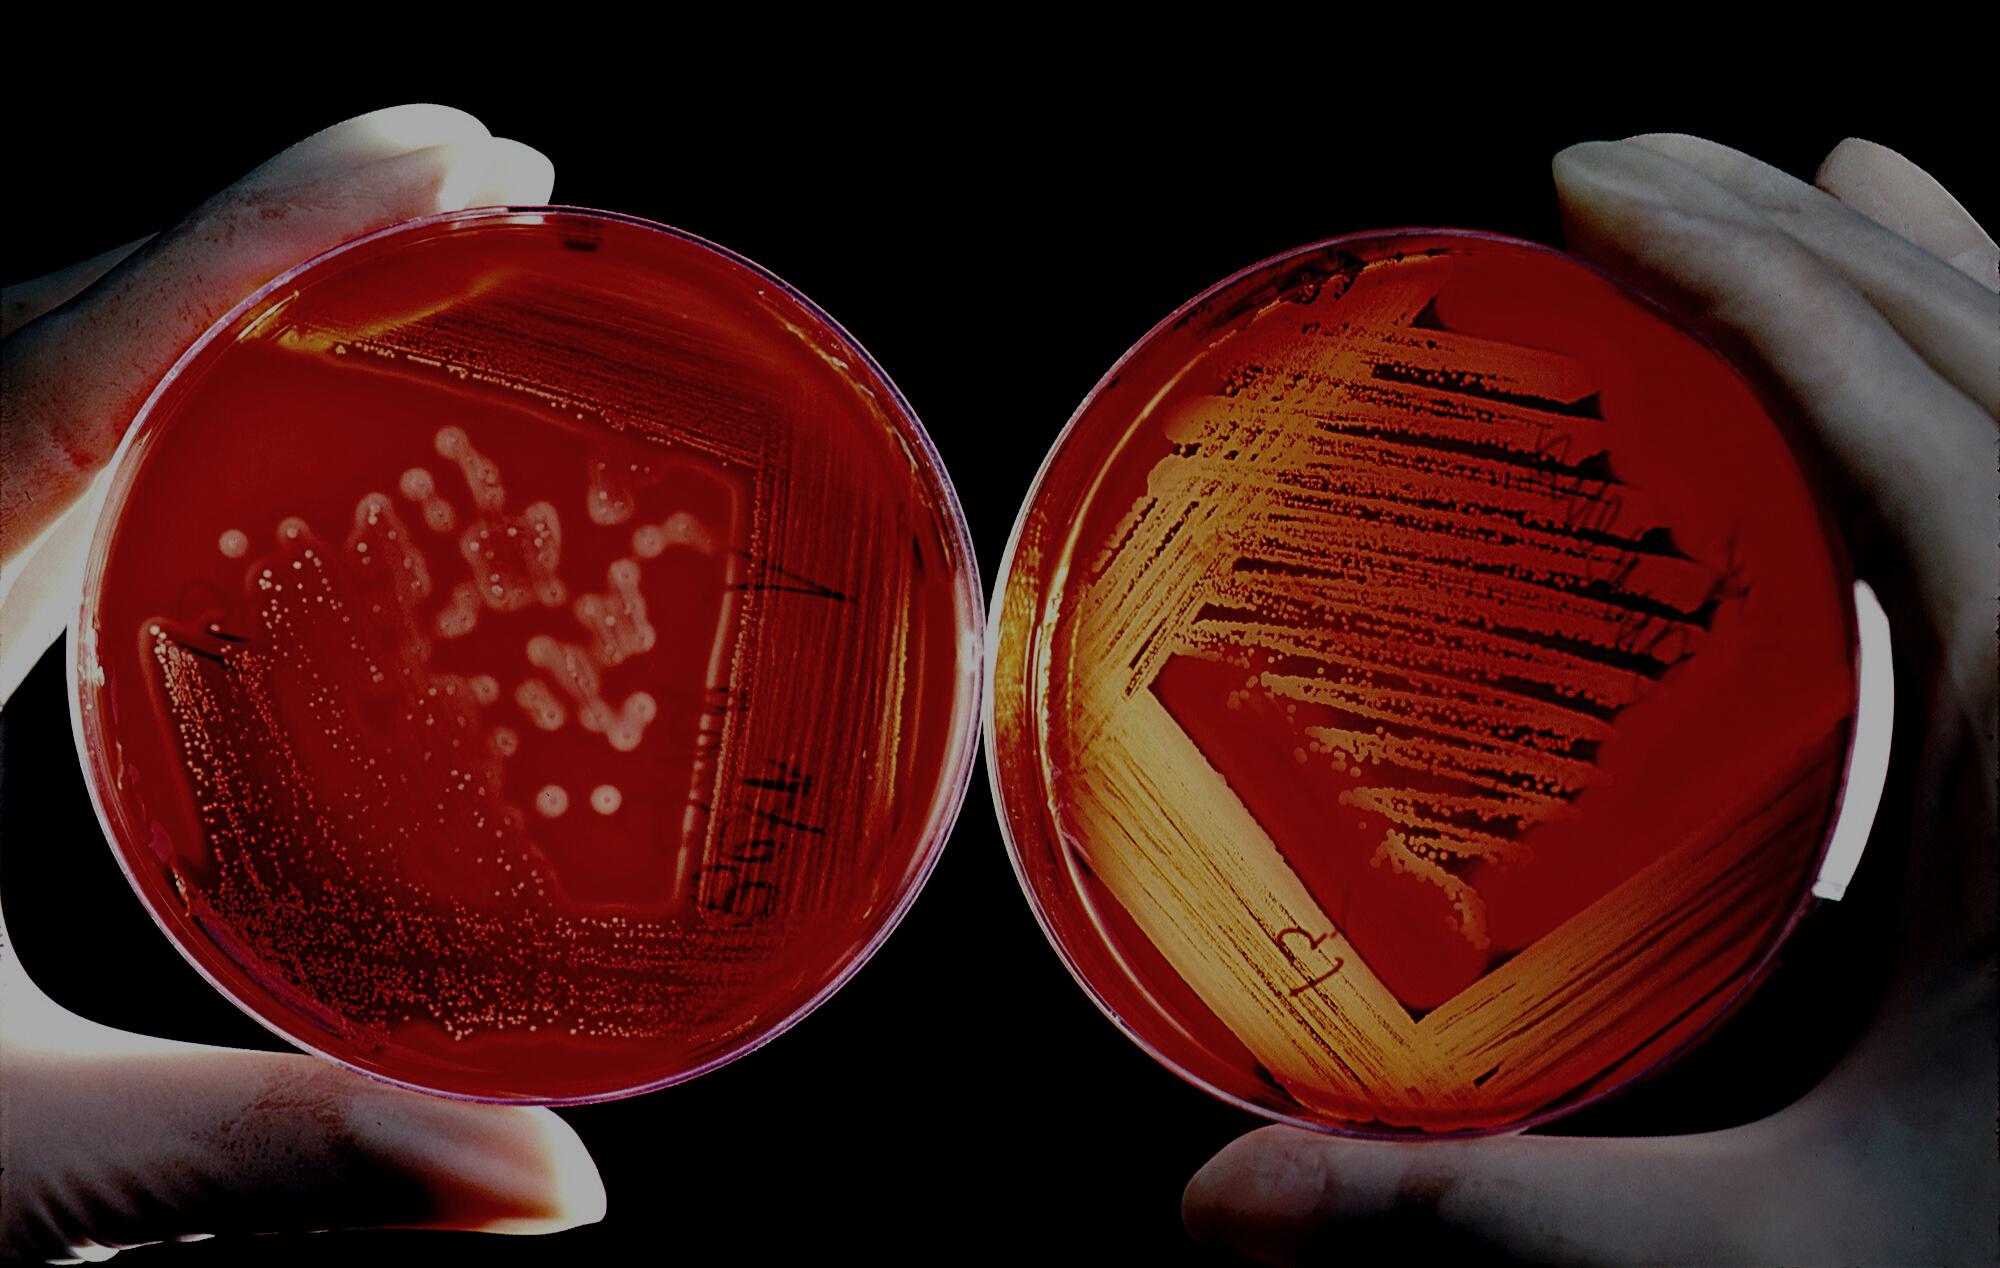

COVID-19
COVID-19, the disease caused by the novel coronavirus, has taken the world by storm. The virus has wreaked havoc on the global economy, caused widespread social disruption, and claimed millions of lives. One aspect of the disease that has received increasing attention is its impact on heart health. COVID-19 has been found to have a significant effect on the cardiovascular system, with a range of consequences that can be serious or even fatal.

https://rammangalhf.com/

Dr. Ranjit Jagtap
Dr. Ranjit Jagtap

